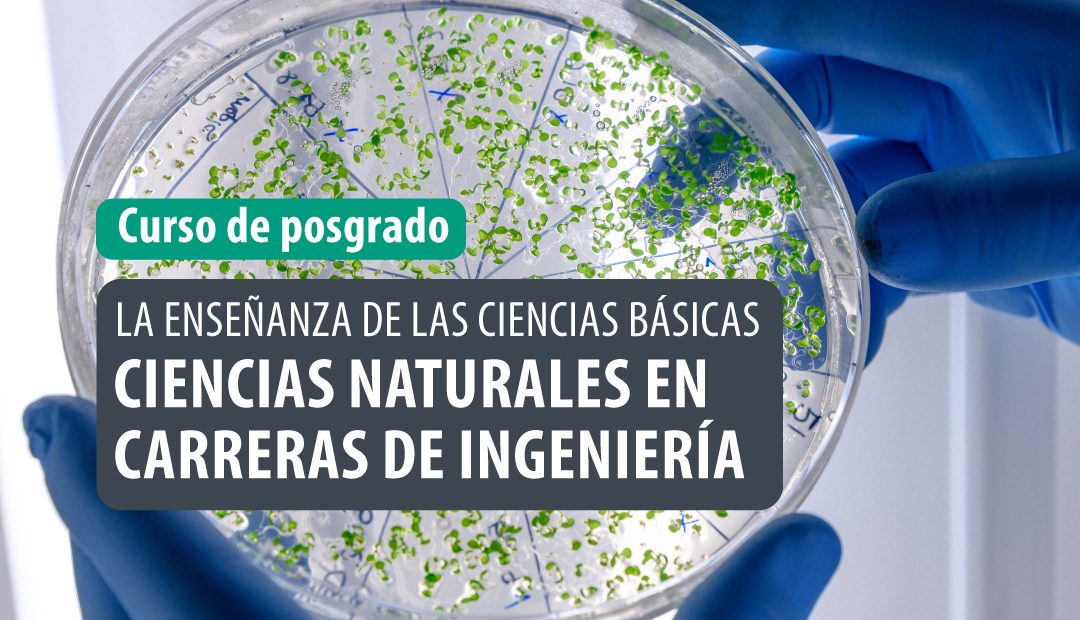

Nuestros cursos se enmarcan en la implementación de una propuesta académica de actualización, capacitación y perfeccionamiento de profesionales, docentes y graduados.
Cursos
El 19 de marzo de 2026 comienza el Curso de posgrado “Epistemología y metaciencias...
El 17 de marzode 2026 comienza el Curso de posgrado “Procesamiento Digital de señales...
El 10 de abril de 2026 comienza el Curso de posgrado “Fundamentos de programación...
El 6 de noviembre de 2025 comienza el Curso de posgrado “La enseñanza de...
El 28 de octubre de 2025 comienza el Curso de posgrado “Ingeniería de Software...
El 13 de octubre de 2025 comienza el Curso de posgrado “Procesos industriales”. Inscripciones...